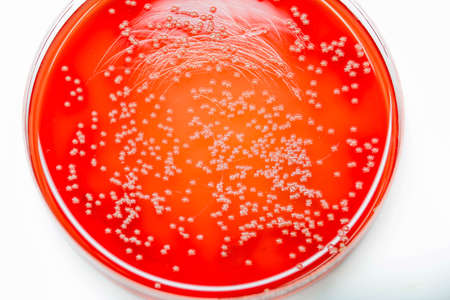
Bacterial colonies culture on Blood agar(gram positive cocci in clusters)contains small light grains. Focus on all agar surface.の写真素材

写真素材 - Bacterial colonies culture on Blood agar(gram positive cocci in clusters)contains small light grains. Focus on all agar surface.
作品情報
Bacterial colonies culture on Blood agar(gram positive cocci in clusters)contains small light grains. Focus on all agar surface.
- ID:99218034
- 作品種別:写真
- 作者名:Sirirat Makprasert
キーワード
- Media
- agar
- air
- aureus
- background
- bacteria
- bacterial
- bacterium
- biology
- biotechnology
- black
- blood
- cell
- colony
- color
- culture
- danger
- diagnostic
- disc
- fecal
- growth
- health
- healthcare
- hygiene
- isolate
- isolated
- isolation
- lab
- laboratory
- medical
- medicine
- medium
- micro
- microbe
- microbiology
- pathogen
- pathogens
- petri
- plate
- plates
- red
- research
- risk
- safety
- science
- scientific
- streak
- test
- treat
- urine
- yellow
類似作品
Staphylococcus ...
iron textures
Staphylococcus ...
Two Petri dishe...
The mesmerizing...
Salmonella ente...
This image show...
Listeria, bacte...
Bacterial cultu...
Bacterium.
Laboratory tabl...
Salmonella ente...
microscope slid...
microbial cultu...
microbiology la...
petri dish with...
Microbiology Sc...
Bacterial and m...
A glass dish wi...
Colonies of bac...
close-up of vib...
A close-up of a...
Two Petri dishe...
Doctors hands h...
Closeup shot of...
A tray filled w...
Abstract colore...
An artistic dis...
Red bubbles of ...
bacteria colony...
close-up of vib...
Red on a blue. ...
Colorful variet...
Bacterial cultu...
Hand in blue gl...
Bacterial cultu...
Close up the me...
close up of pet...
Bacterial colon...
petri dish with...
Bacterial colon...
Background with...
Backgrounds of ...
Drops of blood ...
Mitosis in earl...
Colonies of bac...
biologist or vi...
Red patterns fr...
Drops of blood ...